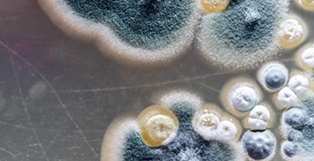

Pleśń i grzyby to jedne z najbardziej uciążliwych problemów występujących w domach, mieszkaniach oraz budynkach użytkowych. Oprócz tego, że wyglądają nieestetycznie, mogą również negatywnie wpływać na zdrowie mieszkańców oraz konstrukcję obiektu. Warto wiedzieć, skąd biorą się te mikroorganizmy i jakie działania są naprawdę skuteczne w ich eliminacji.
Główną przyczyną powstawania pleśni jest nadmierna wilgotność. Najczęściej wynika ona z:
słabej wentylacji pomieszczeń, nieszczelnych okien lub mostków termicznych, zalania lub podciekającej instalacji wodnej, suszenia prania w domu, niewłaściwej izolacji budynku, zbyt rzadkiego ogrzewania.
Kiedy w powietrzu utrzymuje się wilgotność powyżej 60%, a temperatura jest umiarkowana, pleśń zaczyna szybko się rozwijać. Jej zarodniki rozprzestrzeniają się po całym domu, co wpływa zarówno na zdrowie, jak i na stan techniczny budynku.
Pleśń może powodować: problemy z układem oddechowym, alergie i podrażnienia skóry, osłabienie odporności, bóle głowy i złe samopoczucie, uszkodzenie ścian, tynków i mebli.
Dlatego nie warto jej bagatelizować – im szybciej usuniemy problem, tym łatwiej go opanować.
Zlikwidowanie pleśni ma sens tylko wtedy, gdy usuniemy także jej źródło. Może to wymagać: poprawy wentylacji, uszczelnienia okien, naprawy przecieków, docieplenia ścian, używania pochłaniaczy wilgoci lub osuszaczy.
Widoczne ogniska pleśni trzeba dokładnie oczyścić. Najczęściej robi się to poprzez: zdrapanie porażonego tynku, szlifowanie powierzchni, czyszczenie szczotką.
To krok przygotowawczy – sam w sobie nie eliminuje zarodników.
Aby usunąć pleśń skutecznie i długotrwale, konieczne jest użycie specjalistycznych preparatów o działaniu grzybobójczym i biobójczym.
W Pest ExTerminator Siedlce stosujemy m.in.:
Zamgławianie ULV, Opryski chemiczne, Ozonowanie dezynfekcję preparatami o potwierdzonej skuteczności, neutralizację zarodników w powietrzu i na powierzchniach.
Takie metody działają nie tylko na widoczny nalot, ale też na niewidoczne zarodniki unoszące się w powietrzu.
Po usunięciu pleśni warto zabezpieczyć miejsce: preparatami antygrzybicznymi, farbami z dodatkiem biocydów, poprawą mikroklimatu pomieszczenia. Dzięki temu problem nie wróci.
Jeśli: pleśń pojawia się regularnie, zajmuje duże powierzchnie, ma intensywny zapach, występuje w trudnodostępnych miejscach, dom był zalany, chcesz mieć pewność, że problem nie wróci,
najbezpieczniej skorzystać z usług profesjonalnej firmy, która oceni przyczynę i dobierze odpowiednią metodę zwalczania.
1. Pleśnie często wywołują alergię.Uczulenie dotyczy ok. 10% osób i może prowadzić do kataru, kichania, duszności, astmy czy zapalenia spojówek.
2. Najbardziej uczulają pleśnie zewnętrzne – Alternaria i Cladosporium.Najwięcej zarodników jest od czerwca do sierpnia, zwłaszcza przy wysokiej wilgotności.
3. Można ograniczyć kontakt z pleśniami na zewnątrz.Unikaj koszenia trawy, grabienia liści i prac w ogrodzie, gdy stężenie zarodników jest wysokie.
4. Pleśnie wewnątrzdomowe rozwijają się w wilgoci.Spotkasz je w łazienkach, piwnicach, kuchniach, klimatyzacji i na zepsutych produktach.
5. Pleśnie są też w pracy i miejscach publicznych.Baseny, sauny, stare budynki i zawody takie jak rolnik czy piekarz niosą większe ryzyko.
6. Można zmniejszyć ich ilość w domu.Dbaj o wentylację, unikaj nawilżaczy, tapet i roślin doniczkowych, szybko wyrzucaj odpady.
Jako specjalista od DDD oferuję skuteczne i bezpieczne metody likwidacji pleśni i grzybów w mieszkaniach, domach i budynkach użytkowych.
Profesjonalne środki i sprzęt. Dokładna ocena przyczyny wilgoci. Skuteczność potwierdzona praktyką.
Szybka pomoc na terenie Siedlec i okolic
Jeśli masz problem z pleśnią – nie czekaj, aż się rozrośnie . Zadzwoń po profesjonalną pomoc.